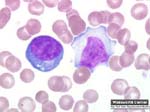
Με τη λοιμώδη μονοπυρήνωση σχετίζεται η σκλήρυνση κατά πλάκας

Δωρεάν παροχή Κοινωνικού Λειτουργού σε ασθενείς με σκλήρυνση κατά πλάκας
Αθήνα: O Σύλλογος Ατόμων με Σκλήρυνση κατά Πλάκας ενισχύει περαιτέρω το επίπεδο των υπηρεσιών που προσφέρει τόσο στα άτομα που πάσχουν από Σκλήρυνση κατά Πλάκας όσο και στο περιβάλλον τους ξεκινώντας συνεργασία με Κοινωνική Λειτουργό.

Αριθμός Πιστοποίησης Μ.Η.Τ.232442
Αριθμός Πιστοποίησης Μ.Η.Τ.232442